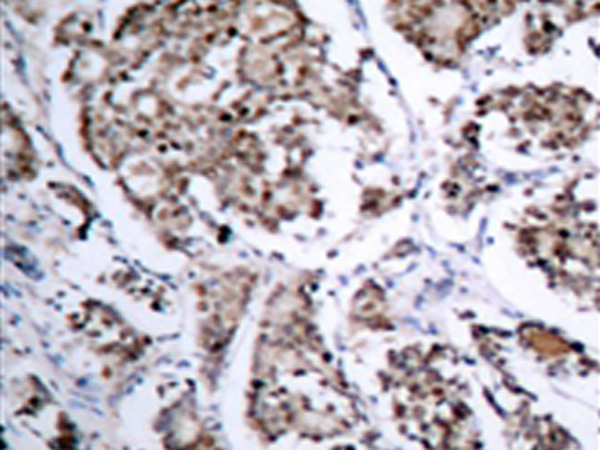

中文名稱:兔抗Bad(Phospho-Ser155)多克隆抗體
|
Background: |
Promotes cell death. Successfully competes for the binding to Bcl-X(L), Bcl-2 and Bcl-W, thereby affecting the level of heterodimerization of these proteins with BAX. Can reverse the death repressor activity of Bcl-X(L), but not that of Bcl-2. Appears to act as a link between growth factor receptor signaling and the apoptotic pathways. |
|
Applications: |
WB, IHC |
|
Name of antibody: |
Bad(Phospho-Ser155) |
|
Immunogen: |
Peptide sequence around phosphorylation site of serine 155(R-M-S(p)-D-E) derived from Human BAD. |
|
Full name: |
BCL2-associated agonist of cell death |
|
Synonyms: |
Bbc2; AI325008 |
|
SwissProt: |
Q61337 |
|
IHC positive control: |
Human breast carcinoma tissue |
|
IHC Recommend dilution: |
50-100 |
|
WB Predicted band size: |
22 kDa |
|
WB Positive control: |
293 cells lysate |
|
WB Recommended dilution: |
500-1000 |

購物車
購物車 幫助
幫助
 021-54845833/15800441009
021-54845833/15800441009
